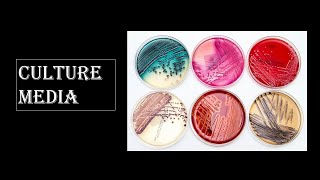

Hello everyone!
I am Israt Ara, Currently an MBBS student of Dhaka Medical College & Hospital,Session:2017-18. I love to gather knowledge & spread it wherever I can. Besides study, I work at various volunteering organizations, social platforms. Climate change, Blood donation, Underprivileged children, Leadership skill development, Communication, Networking, Human Resource Management, Public Speaking & there are many more sectors I am now working on.
Stay connected with me. Don't forget to subscribe to my channel to get more study tutorials, life lesson & many more amazing contents.
Thank you!
Shared 4 years ago
16 views
Shared 4 years ago
7 views
Shared 4 years ago
7 views
Shared 4 years ago
8 views
Shared 4 years ago
4 views
Shared 4 years ago
6 views
Shared 4 years ago
14 views
Shared 4 years ago
31 views
Shared 4 years ago
17 views
Shared 4 years ago
90 views
Shared 4 years ago
31 views
Shared 4 years ago
21 views
Shared 4 years ago
23 views
Shared 4 years ago
52 views
Shared 4 years ago
69 views
Shared 4 years ago
31 views
Shared 4 years ago
52 views
Shared 4 years ago
40 views
Shared 4 years ago
317 views
Shared 4 years ago
36 views